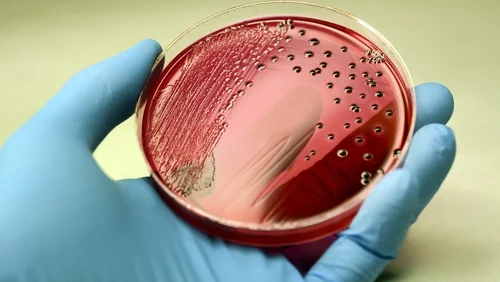
ما هو تعفن الدم وما الفرق بينه وبين إنتان الدم وكيف يمكن علاجه؟

ما هو تعفن الدم وما الفرق بينه وبين إنتان الدم وكيف يمكن علاجه؟
تعفن الدم من الحالات الطبية الطارئة التي تهدد الحياة، ويحتاج المريض فيها إلى تدخل طبي عاجل لإنقاذ حياته. على الرغم من أن مصطلح تعفن الدم (Sepsis) أصبح معروفًا إلى حد ما بين الناس، إلا أن هناك خلطًا شائعًا بينه وبين إنتان الدم (Bacteremia). في هذا المقال، سنوضح معنى كل منهما، الفرق بينهما، الأسباب، الأعراض، التشخيص، والعلاج، مع التركيز على أهمية الوقاية والتدخل الطبي المبكر.

أولاً: ما هو تعفن الدم؟
تعفن الدم، أو الإنتان الجهازي (Sepsis)، هو استجابة الجسم المفرطة لعدوى، سواء كانت بكتيرية، فيروسية، فطرية، أو طفيلية، تؤدي إلى اضطراب واسع النطاق في وظائف الأعضاء. عندما يبالغ الجسم في الاستجابة المناعية، يمكن أن تسبب الالتهابات انخفاض ضغط الدم، فشل الأعضاء، وحتى الموت إذا لم يتم التدخل بسرعة.
كيف يحدث تعفن الدم؟
عند دخول الجراثيم أو مسببات العدوى إلى الجسم، يطلق الجهاز المناعي مواد كيميائية لمحاربتها. في بعض الحالات، تخرج هذه الاستجابة عن السيطرة، فتسبب:
التهابًا منتشرًا في الجسم.
تخثر الدم الجزئي.
انخفاض ضغط الدم الحاد.
فشل الأعضاء الحيوية مثل الكلى والكبد والرئتين.
مسببات تعفن الدم
أكثر مسببات تعفن الدم شيوعًا هي:
البكتيريا: مثل المكورات العنقودية (Staphylococcus aureus) والإشريكية القولونية (E. coli).
الفيروسات: مثل الإنفلونزا أو فيروس كورونا (COVID-19) في حالات شديدة.
الفطريات: مثل الكانديدا (Candida species) لدى المرضى ضعاف المناعة.
الطفيليات: مثل الملاريا في المناطق الموبوءة.
الفئات الأكثر عرضة
بعض الفئات معرضة أكثر للإصابة بتعفن الدم، مثل:
كبار السن.
الأطفال الرضع.
المرضى المصابين بأمراض مزمنة مثل السكري أو أمراض القلب والكلى.
الأشخاص الذين يعانون ضعف المناعة، بما في ذلك مرضى السرطان أو من يتناولون أدوية مثبطة للمناعة.
المرضى الذين أجروا عمليات جراحية أو لديهم قسطرة أو أجهزة طبية داخلية.
ثانيًا: ما هو إنتان الدم؟
إنتان الدم (Bacteremia) هو وجود البكتيريا في الدم، وقد يحدث نتيجة عدوى موضعية في الجسم، مثل:
عدوى المسالك البولية.
الالتهابات الجلدية أو الجروح.
الالتهاب الرئوي.
الفرق الأساسي بين إنتان الدم وتعفن الدم
الخاصية إنتان الدم (Bacteremia) تعفن الدم (Sepsis)
التعريف وجود البكتيريا في الدم استجابة الجسم الالتهابية المفرطة لعدوى تؤدي إلى فشل أعضاء
خطورة الحالة غالبًا مؤقتة ويمكن السيطرة عليها حالة طارئة قد تؤدي إلى الموت إذا لم تُعالج بسرعة
الأعراض غالبًا لا تظهر أعراض أو حرارة منخفضة أو ارتفاع بسيط حمى أو برودة شديدة، انخفاض ضغط الدم، تسارع ضربات القلب، صعوبة التنفس
النتيجة يمكن أن تختفي بالإجراءات البسيطة مثل المضاد الحيوي قد تتطور بسرعة إلى صدمة إنتانية وفشل أعضاء متعدد
إذًا، يمكن القول إن إنتان الدم قد يكون السبب الذي يؤدي إلى تعفن الدم، لكنه ليس بالضرورة يؤدي إليه في كل الحالات. فوجود البكتيريا في الدم لا يعني دائمًا أن الجسم سيستجيب بشكل مفرط.
ثالثًا: أعراض تعفن الدم
تتفاوت أعراض تعفن الدم حسب شدة الحالة وسرعة التدخل الطبي، وأهمها:
أعراض عامة:
الحمى أو انخفاض الحرارة عن المعدل الطبيعي.
القشعريرة والتعرق الغزير.
الشعور بالإرهاق الشديد أو الضعف.
الارتباك الذهني أو صعوبة التركيز.
أعراض جهازية:
تسارع ضربات القلب.
انخفاض ضغط الدم، وقد يؤدي إلى صدمة إنتانية.
تسارع التنفس أو ضيق النفس.
أعراض فشل الأعضاء:
الكلى: قلة التبول أو توقفه.
الكبد: اصفرار الجلد والعينين (اليرقان).
الرئتين: صعوبة التنفس أو تراكم السوائل.
القلب: انخفاض ضغط الدم رغم تلقي السوائل.
يجب التعامل مع هذه الأعراض كحالة طارئة، والتوجه فورًا إلى أقرب مستشفى مجهز للعناية المركزة.
رابعًا: التشخيص
يعتمد تشخيص تعفن الدم على مجموعة من الفحوصات السريرية والمخبرية، مثل:
الفحص السريري:
قياس درجة الحرارة وضغط الدم ونبض القلب والتنفس.
تقييم مستوى الوعي والتركيز.
تحاليل الدم:
تعداد الدم الكامل (CBC) لمعرفة وجود عدوى أو انخفاض كريات الدم البيضاء.
زراعة الدم (Blood Culture) لتحديد نوع البكتيريا.
قياس علامات الالتهاب مثل البروتين التفاعلي (CRP) والبروكالسيتونين (PCT).
فحوصات أخرى:
وظائف الكلى والكبد.
صورة الأشعة أو الأشعة المقطعية لتحديد مصدر العدوى.
تحاليل البول أو الإفرازات الأخرى حسب مصدر العدوى المشتبه به.
خامسًا: علاج تعفن الدم وإنتان الدم
1. العلاج المبكر بالمضادات الحيوية
استخدام مضاد حيوي واسع المجال بشكل عاجل بعد أخذ عينات الدم للزراعة.
تعديل المضاد الحيوي لاحقًا وفق نتائج زراعة الدم وحساسية البكتيريا.
مدة العلاج عادة 7-14 يومًا حسب شدة العدوى واستجابة المريض.
2. دعم الأجهزة الحيوية
إعطاء السوائل الوريدية لتعويض انخفاض ضغط الدم.
في بعض الحالات، يحتاج المريض إلى أدوية مقوية لضغط الدم (Vasopressors).
دعم التنفس بواسطة أجهزة التنفس الصناعي عند فشل الرئتين.
متابعة وظائف الكلى، وقد يحتاج المريض غسيل كلوي مؤقت.
3. التحكم بمصدر العدوى
إزالة القسطرة أو الأجهزة الطبية المصابة.
معالجة الجروح أو الخراجات أو الالتهابات الموضعية بالجراحة إذا لزم الأمر.
علاج أي عدوى أولية مثل الالتهاب الرئوي أو التهاب المسالك البولية.
4. الرعاية في وحدة العناية المركزة
المرضى المصابون بتعفن الدم الشديد يحتاجون إلى متابعة دقيقة على مدار الساعة.
مراقبة ضغط الدم، معدل ضربات القلب، وظائف الكبد والكلى، التنفس، ومستوى الأكسجين.
استخدام تقنيات حديثة لدعم الحياة إذا لزم الأمر.
سادسًا: الوقاية
الوقاية من تعفن الدم وإنتان الدم ممكنة باتباع خطوات بسيطة، خصوصًا للفئات الأكثر عرضة:
التطعيمات:
لقاحات الإنفلونزا، المكورات الرئوية، المكورات السحائية، وغيرها.
النظافة الشخصية:
غسل اليدين بانتظام، وتنظيف الجروح بشكل صحيح.
المتابعة الطبية للأمراض المزمنة:
التحكم في السكري وارتفاع ضغط الدم وأمراض القلب.
التعامل السريع مع العدوى:
عدم تجاهل الحمى أو الالتهابات الجلدية أو التهابات المسالك البولية.
التوعية الأسرية:
تعليم الأطفال وكبار السن علامات التحذير المبكر لتعفن الدم.
سابعًا: مضاعفات تعفن الدم
في حال التأخر في العلاج، يمكن أن يؤدي تعفن الدم إلى مضاعفات خطيرة مثل:
صدمة إنتانية: انخفاض حاد في ضغط الدم يؤدي إلى ضعف وصول الدم إلى الأعضاء الحيوية.
فشل متعدد الأعضاء: فشل الكبد، الكلى، القلب أو الرئتين.
تجلط الدم المفرط: يمكن أن يؤدي إلى نزيف داخلي أو انسداد الأوعية.
الموت: تصل نسبة الوفاة في الحالات الشديدة إلى 20-50% حسب سرعة التدخل الطبي.
ثامنًا: الفرق الجوهري بين إنتان الدم وتعفن الدم
لتوضيح الفرق النهائي:
إنتان الدم: وجود الجراثيم في الدم، قد يكون بدون أعراض خطيرة، ويمكن أن يُعالج بسرعة بالمضادات الحيوية.
تعفن الدم: استجابة الجسم الالتهابية المفرطة للعدوى، تؤدي إلى أعراض خطيرة وفشل أعضاء محتمل، وتتطلب رعاية عاجلة ومكثفة.
باختصار: كل حالة تعفن دم تبدأ غالبًا من إنتان دم أو عدوى موضعية، لكن ليس كل إنتان دم يؤدي إلى تعفن الدم. السرعة في التشخيص والعلاج هي العامل الحاسم في النجاة.
تعفن الدم حالة طارئة تهدد الحياة، بينما إنتان الدم يمثل وجود البكتيريا في الدم. الفرق الأساسي يكمن في شدة استجابة الجسم والضرر الذي تسببه على الأعضاء. الوقاية، التشخيص المبكر، العلاج بالمضادات الحيوية، ودعم الوظائف الحيوية هي المفاتيح الأساسية لإنقاذ حياة المرضى.
الوعي بأعراض تعفن الدم، مثل الحمى أو انخفاض الحرارة، تسارع ضربات القلب، صعوبة التنفس، أو ارتباك الذهن، يمكن أن ينقذ حياة الكثيرين، خاصة الفئات الأكثر عرضة ككبار السن والأطفال والمرضى المزمنين.
في عالم الطب الحديث، كل دقيقة تؤخر العلاج قد تكون حاسمة، لذلك يُعد التوجه الفوري للطوارئ والتعامل السريع مع العدوى هو الطريق الأمثل للنجاة من تعفن الدم.